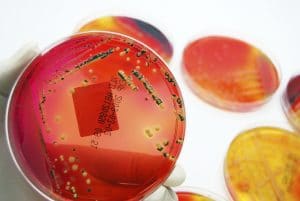

Mikrobiyoloji Laboratuvarımızda su, havuz suyu, atık su, deniz suyu, balık çiftlikleri, atık, çalışma ortamında aşağıda belirtilen mikro-biyolojik analizler membran filtrasyon ve çoklu tüp yöntemleri ile gerçekleştirilmektedir.
- Toplam Koliform Bakterileri
• Fekal Koliform Bakterileri
• Escherichia Coli
• Fekal Enterekokların (Fekal Streptokok)
• Sülfit İndirgeyen Anaerobik Bakteri Sporları
• Clostridium perfringens
• Salmonella spp
• Koloni (22 ◦C ve 37 ◦C’ de)
• Toplam Bakteri
• Pseudomonas aeruginosa
• Legionella
• Küf-Maya